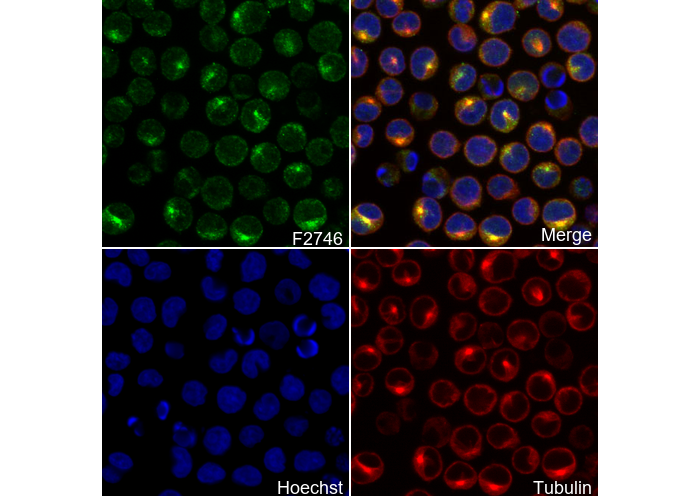

- 抑制剂
- 化合物库
- 热卖化合物库
- 定制您的化合物库
- 临床和上市相关
- 活性化合物总库
- 抑制剂相关
- 天然产物和药食同源相关
- 代谢相关
- 细胞死亡相关
- 按信号通路分类
- 按疾病分类
- 抗感染和抗病毒相关
- 神经和免疫相关
- 片段和共价相关
- 定制库
- FDA药物库
- 临床I期后及FDA药物库
- 临床前和临床药物库
- 已知活性药物库-I
- 生物活性库Ⅱ
- 激酶抑制剂库
- 多样性化合物母核库
- 天然产物库
- 人内源代谢化合物库
- 生物碱类化合物库New
- 血管生成相关化合物库
- 抗衰老化合物库
- 抗阿尔茨海默病化合物库
- 抗生素化合物库
- 抗肿瘤化合物库
- 抗癌化合物库-Ⅱ
- 抗癌代谢化合物库
- 抗心血管疾病化合物库
- 抗糖尿病化合物库
- 抗感染化合物库
- 抗氧化化合物库
- 抗寄生虫药物库
- 抗病毒化合物库
- 凋亡分子化合物库
- 自噬化合物库
- 钙通道阻滞剂库New
- Cambridge抗癌化合物库
- 糖代谢化合物库New
- 细胞周期化合物库
- 血脑屏障通透化合物库
- 共价抑制剂库
- 细胞因子抑制剂库New
- 细胞骨架信号通路化合物库
- DNA损伤/ DNA修复化合物库
- 类药性化合物库
- 内质网应激库
- 表观遗传化合物库
- 外泌体分泌相关化合物库New
- FDA抗癌药物库New
- 铁死亡化合物库
- 黄酮类化合物库
- 片段库
- 谷氨酰胺代谢化合物库
- 糖酵解化合物库
- GPCR小分子化合物库
- 肠道微生物代谢物库
- HIF-1信号通路化合物库
- 高选择性抑制剂库
- 组蛋白修饰化合物库
- 新药发现高通量筛选库
- 人类激素相关化合物库New
- 人转录因子化合物库New
- 免疫/炎症分子化合物库
- 抑制剂库
- 离子通道配体库
- JAK-STAT信号通路库
- 脂代谢化合物库New
- 大环化合物库
- MAPK抑制剂库
- 药食同源化合物库
- 代谢化合物库
- 甲基化化合物库
- 小鼠代谢化合物库New
- 天然有机化合物库
- 神经信号化合物库
- NF-κB信号通路库
- 核苷类似物库
- 肥胖化合物库
- 氧化应激化合物库New
- 植物提取物库
- 表型筛选库
- PI3K/Akt 抑制剂库
- 蛋白酶抑制剂库
- 蛋白-蛋白互作(PPI)抑制剂库
- 细胞焦亡化合物库
- 小分子免疫肿瘤化合物库
- 线粒体靶向化合物库New
- 干细胞分化化合物库New
- 干细胞小分子化合物库
- 天然酚类化合物库New
- 天然萜类化合物库New
- TGF-beta/Smad信号通路库
- 中药化合物库
- 酪氨酸激酶抑制剂分子库
- 泛素化化合物库
- 定制化合物库-1
- 定制化合物库-2
- 定制化合物库-3
- 定制化合物库-4
- 定制化合物库-5
- 定制化合物库-6
-
定制您的化合物库
通过在我们的库存中挑选化合物来建立合适的化合物库,用于您的研究工作。
请通过info@selleck.cn与我们联系,定制你所需要的化合物库。
您可以选择:
- 抗体
- 生物试剂
- 新产品
- 联系我们
GGT1/GGT Antibody [N21M12]
目录号: F2746
抗体应用:
反应性:
使用信息
| 稀释比例 |
|---|
|
| 抗体应用 |
|---|
| WB, IHC, IF, FCM |
| 反应性 |
|---|
| Mouse, Human |
| 抗体类型 |
|---|
| Mouse Monoclonal Antibody |
| 储存液配方 |
|---|
| PBS, pH 7.2+50% Glycerol+0.05% BSA+0.01% NaN3 |
| 储存条件(自收到货起) |
|---|
| -20°C (avoid freeze-thaw cycles), 2 years |
|
预测分子量
|
|---|
|
61 kDa
|
| 阳性对照 | Human testis; HepG2 cell; HEK293 cell; NIH/3T3 cell |
|---|---|
| 阴性对照 |
实验方法
| WB |
|---|
实验步骤: 样品制备
1. 组织样品:破碎组织,加入适量冰冷的 RIPA/NP-40 Lysis Buffer (含蛋白酶抑制剂Cocktail),低温匀浆或置于冰上超声裂解样品,静置30 min。 2. 贴壁细胞样品:吸去培养基, 用冰冷的 PBS 清洗细胞 2 遍。加入适量冰冷的 RIPA/NP-40 Lysis Buffer (含蛋白酶抑制剂Cocktail),超声处理以裂解细胞,并在冰上孵育 30 分钟。 3. 悬浮细胞样品:将培养基转移至离心管中离心,弃上清,用冰冷的 PBS 清洗细胞 2 遍。加入适量冰冷的 RIPA/NP-40 Lysis Buffer (含蛋白酶抑制剂Cocktail),超声处理以裂解细胞,并在冰上孵育 30 分钟。 4. 将所得匀浆液/裂解液置于离心机中 4°C 离心 15 min,收集上清液;
5. 取少量裂解液测定蛋白质浓度;
6. 加入蛋白上样缓冲液,将 20 µL样品在 95~100°C加热 5 min,冰上静置冷却后离心 5 min。
电泳分离
1. 根据所提蛋白的浓度,将适量蛋白样品和 Marker 上样至 SDS-PAGE 凝胶。建议分离胶(即下层胶)浓度:10 %。 SDS-PAGE 分离胶浓度选择参照表 2. 电源调 80 V, 30 min。然后电源调 110 V~150 V,观察 Marker,待蛋白所在的预染蛋白 Marker 指示带得到合适的分离后,即可停止电泳。(注意电泳时电流切勿过大,如超过 150 mA 会导致温度上升,容易影响跑胶结果。如无法避免采用大电流,可对电泳槽使用冰浴降温。)
转膜
1.拿出电转槽,把夹子和耗材浸泡在预冷电转液中;
2.用甲醇活化 PVDF 膜 1 min,用转移缓冲液冲洗;
3.按照“夹子黑边-海绵-滤纸-滤纸-胶-PVDF膜-滤纸-滤纸-海绵-夹子白边”的顺序安装好; 4.将蛋白电转移至 PVDF膜上。(推荐采用 0.45 µm PVDF 膜) PVDF 膜孔径规格选择参照表 湿转法参考条件:200 mA, 120 min。
(注意电转条件可根据蛋白大小适当调节,分子量大的蛋白适宜采用大电流,并延长转膜时间,但需要确保电转槽始终处于低温的环境中,避免凝胶融化。)
封闭
1. 电转移后,室温下用 TBST 洗膜 5 min;
2. 在封闭液中将膜孵育 1 h,室温;
3. 用 TBST 洗膜 3 次,每次 5 min。
抗体孵育 1. 用 一抗稀释液配制一抗工作液(建议一抗稀释比 1:1000),4°C 条件下与膜轻柔摇晃孵育过夜; 2. 用 TBST 洗膜 3 次,每次 5 min;
3. 在封闭液中加入二抗,室温条件下与膜轻柔摇晃孵育 1 h;
4. 孵育结束后,用 TBST 洗膜 3 次,每次 5 min。
显色
1. 加入配制好的 ECL 发光底物(或根据二抗选择其他显色基质)混合均匀;
2. 与膜孵育1 min,去除多余底物(需保持膜湿润),置于显影仪中进行曝光。
|
| IF |
|---|
实验步骤:
样品准备
1. 贴壁细胞:取洁净无菌盖玻片置于培养皿中,待细胞接近长成单层后取出盖玻片。
2. 悬浮细胞:将细胞接种至多聚赖氨酸包被的洁净无菌载玻片上。
3. 冰冻切片:将玻片置于室温下解冻,纯水或 PBS 摇洗 3次,每次 3 min。
4. 石蜡切片:先将玻片脱蜡至水,纯水或 PBS 摇洗 3次,每次 3 min。然后进行抗原修复。
固定
1. 使用固定液,如4%多聚甲醛(4% PFA)室温固定细胞爬片/涂片或组织切片 10~15 min。
2. 使用 PBS 摇洗样品 3次,每次 3 min。
通透
1. 对样品添加去垢剂,如 0.1~0.3% Triton X-100,室温通透 10~20 min。
(仅针对胞内抗原,若是细胞膜上表达的抗原则可省略该步骤。)
2. 使用 PBS 摇洗样品 3次,每次 3 min。
封闭
添加封闭液,在室温下封闭至少 1 h。(常用的封闭液包括:与二抗同一来源的血清、BSA或山羊血清。)
注意事项:从封闭开始之后的所有步骤务必保证样品湿润,避免干燥,否则极易产生高背景。
免疫荧光染色(第一天)
1. 吸走封闭液,滴加稀释后的一抗。
2. 湿盒中 4°C 孵育过夜。
免疫荧光染色(第二天)
1. 吸走一抗,PBST 摇洗 3 次,每次 5 min。
2. 滴加稀释后的荧光二抗,避光 4°C 孵育 1~2 h。
3. 吸走二抗,PBST 摇洗 3 次,每次 5 min。
4. 滴加稀释后的 DAPI,室温避光 孵育 5~10 min。
5. PBST 中摇洗 3 次,每次 5 分钟。
封片
1. 抗荧光淬灭封片剂封片。
2. 干燥玻片,将玻片置于室温下避光过夜。
3. 将载玻片放入玻片盒中 4°C 避光保存。
|
| IF |
|---|
实验步骤:
标本制备
1. 吸出液体,然后用 1X PBS 稀释的 4% 多聚甲醛覆盖细胞至 2-3 mm 的深度。
注意:多聚甲醛有毒,只能在通风橱中使用。
2. 室温固定细胞 15 分钟。
3. 吸出固定液,用 1X PBS 冲洗 3 次,每次 5 分钟。
4. 继续进行免疫染色。
免疫染色
1. 添加封闭缓冲液并在室温下孵育 60 分钟。
2. 按照建议在抗体稀释缓冲液中制备一抗稀释液。
3. 吸出封闭液,加入制备好的一抗稀释液。
4. 4°C 孵育过夜。
5. 在 1X PBS 中冲洗 3 次,每次 5 分钟。
6. 将样本放入用抗体稀释缓冲液稀释的荧光染料偶联二抗中,室温避光孵育 1-2 小时。
7. 在 1X PBS 中冲洗 3 次,每次 5 分钟。
8. 使用带有 DAPI 的封固剂封固载玻片并盖上盖玻片。
9. 为获得最佳效果,请让封固剂在室温下固化过夜。 如需长期保存,请将载玻片平放在 23°C 避光保存。
|
| IHC |
|---|
实验步骤:
脱蜡/补液
1. 脱蜡/水合切片:
2. 将切片在二甲苯中孵育 3 次,每次 5 分钟。
3. 将切片在 100% 乙醇中孵育两次,每次 10 分钟。
4. 将切片在 95% 乙醇洗涤液中孵育两次,每次 10 分钟。
5. 用 dH2O 清洗切片两次,每次 5 分钟。
6.抗原修复:对于柠檬酸盐:将载玻片浸入 1X 柠檬酸盐暴露溶液中,在微波炉中加热,直至开始沸腾; 在亚沸温度 (95°-98°C) 下继续煮 10 分钟。 在工作台上冷却玻片 30 分钟。
染色
1. 用 dH2O 清洗切片 3 次,每次 5 分钟。
2. 将切片在 3% 过氧化氢中孵育 10 分钟。
3. 用 dH2O 清洗切片两次,每次 5 分钟。
4. 在洗涤缓冲液中洗涤切片 5 分钟。
5. 用 100–400 µl 封闭液在室温下封闭每个切片 1 小时。
6. 除去封闭液,并向每个切片中添加 100–400 µl 一抗稀释液。 4°C 孵育过夜。
7. 去除抗体溶液,用洗涤缓冲液洗涤切片 3 次,每次 5 分钟。
8. 用 1-3 滴所需的 HRPA 覆盖切片。 在加湿室中室温孵育 30 分钟。
9. 用洗涤缓冲液洗涤切片 3 次,每次 5 分钟。
10. 使用前将 DAB 显色剂浓缩液加入 DAB 稀释液中并充分混合。
11. 在每个切片上涂抹 100–400 µl DAB 并密切监测。 1-10 分钟通常可提供可接受的染色强度。
12. 将载玻片浸入 dH2O 中。
13. 如果需要,用苏木精复染切片。
14. 用 dH2O 清洗切片两次,每次 5 分钟。
15. 切片脱水:95%乙醇孵育切片两次,每次 10 秒; 在 100% 乙醇中重复,孵育切片两次,每次 10 秒; 在二甲苯中重复,孵育切片两次,每次 10 秒。
16. 用盖玻片和封固剂封固切片。
|
生物描述
| 特异性 |
|---|
| GGT1/GGT Antibody [N21M12] 可检测内源性 GGT1/GGT 总蛋白水平。 |
| 蛋白定位 |
|---|
| 细胞膜,内膜系统 |
| Uniprot ID |
|---|
| P19440 |
| 克隆号 |
|---|
| N21M12 |
| 别名 |
|---|
| CD224, GGT, GGT1, Glutathione hydrolase 1 proenzyme, Gamma-glutamyltransferase 1, Gamma-glutamyltranspeptidase 1, Leukotriene-C4 hydrolase, GGT 1 |
| 背景 |
|---|
| γ-谷氨酰转肽酶 (GGT) 是一种广泛分布的酶,属于 N 端亲核水解酶超家族,其特征是 N 端具有负责断裂酰胺键的催化残基。功能上,GGT 催化供体底物上 γ-谷氨酰酰胺键的断裂,并将释放的 γ-谷氨酰基转移至水中(导致水解),或转移至氨基酸和短肽(导致转肽作用)。GGT 位于细胞膜外表面,在谷胱甘肽 (GSH)(细胞内主要的抗氧化硫醇)代谢中发挥核心作用。通过水解细胞外 GSH,GGT 促进半胱氨酸的回收,半胱氨酸是细胞内 GSH 和蛋白质从头合成所必需的前体。通过这种机制,GGT 有助于维持氧化还原平衡,增强细胞对氧化应激的抵抗力,从而支持细胞的快速增殖。值得注意的是,GGT 的表达在炎症状态和多种癌症进展过程中会升高。其失调也与多种氧化应激相关疾病有关,包括心血管疾病和糖尿病。 |
| 参考文献 |
|---|
|
技术支持
在订购、运输、储存和使用我们的产品的任何阶段,您遇到的任何问题,均可以通过拨打我们的热线电话400-668-6834,或者技术支持邮箱tech@selleck.cn,直接联系到我们。我们会在24小时内尽快联系您。
* 必填项